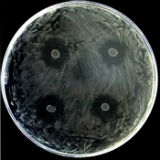

Cómo poner fin a las indeseadas caries
La mayoría de personas, por desgracia, ha sufrido alguna vez el que es el problema bucodental más habitual, es decir, las caries. Sin embargo, y a pesar de ser padecidas por la mayoría, son para una enorme fracción...
La caries podrá prevenirse con chicle, yogur o dentífrico en cinco años
La caries se podrá prevenir en cinco años con chicle, yogur, pasta dentífrica o medicamentos gracias a la incorporación en estos productos de un microorganismo que habita en el cuerpo humano y que ha sido descubierto...

Unas bacterias presentes en la cavidad oral pueden proteger de la caries
La caries es la enfermedad infecciosa más común en todo el mundo y, aunque está condicionada por múltiples factores, estudios recientes han identificado unas bacterias en la cavidad oral que protegen frente...






